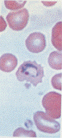

-
-
 골수 천자 검사 골수 천자 검사
- (Bone Marrow Examination)
-
- 1.골수의 구조
-
- 골수는 trabecular bone으로 둘러싸인 부분으로 크게 fat area와 cellular area로 구성되고 세포구역에는 각종 혈구세포와혈관이 분포한다. 골수(bone marrow)는 조혈장기로써 전신의 골수강(bone marrow cavity)내에 존재하며, 중량은 성인에게서는 체중의 3.4∼5.9%정도이고 평균적으로 2600gm (1600∼3700gm)정도이다. 이와같은 골수의 약 절반이 활동성(cellular marrow : 적골수)으로 조혈에 참여하고 있다. 이처럼 골수는 육안적으로도 조혈이 행하여지고 있는 적색 골수 (red marrow 또는 celluler marrow) 와 지방화되어 있는 황색 골수 (yellow marrow 또는 fatty marrow)로 구분 할 수 있다.
-
- 2. 골수의 기능
- 1) 적혈구생성
- 형태학적으로 인지할 수 잇는 가장 초기의 적혈구 세포는 pronormoblast 이고 세포분열을 통해 점점 분화되어 여러단계의 normoblasts를 거쳐서 핵이 빠져나가 망상적혈구가 된다. 이 과정에서 세포질내 hemoglobin합성은 점점 증가하고 RNA는 점차 사라져서 성숙함에 따라 세포질의푸른색이 점점 핑크색이된다. 망상적혈구는 골수내에서 1~2일 존재하다가 말초혈액으로 나오게 되고 더성수되어 RNA가 완전히 없어지고 분홍색으로 염색되는 biconcave disc형태의 성숙한 적혈구가 된다.
-
- (1) Erythropoietin : 신장에서 합성되는 적혈구 생성조절 호르몬으로서 산소분압이 낮으면 호르몬합성이 촉진되어 적혈구 생성을 가속화 시킨다.
-
- (2) Hemoglobin : 각각의 적혈구에는 약 6억 4천만 분자의hemoglobin이 존재하고, 성인의 주요hemoglobin인 hemoglobin A는 한 분자 당 α2ß2 , 4개의 polypetide chain 으로 구성되어 있고, 각각의 polypetide chain은 heme과 연결되어있다. 성인의 hemoglobin에는 Hb A외에도 소량의 Hb F와 Hb A2가 존재한다. fetal hemoglobin에서 성인 hemoglobin으로의 전환은 출생 후 3-6개월 사이에 일어난다. hemoglobin의 합성은 erythroblast에서 약 65%정도 합성된다. 나모지 35%는 reticulocyte 단계에서 합성된다. hemoglobin 중 heme의 합성은 glycine과 succinyl coenzyme A가 결합하며 일련의 생화확적 반응이 일어남으로써, mitochondria에서 생성되며, 이 반응의 시작은 주요 rate-limiting enzyme인 ALA synthetase에 의하여 조절된다. 이렇게 하여 궁극적으로 생성된 protoporphyrin은 철과 결합하여 heme이되고, 각각의 heme molecule은 polyribosome에서 globin chain과 결합하여 tetramer의 hemoglobin이 합성된다.
-
- 2) 백혈구 생성(granulopoiesis)
- (1) 호중구(neutrophil)와 단구(monocyte)
- 호중구와 단구는 공통된 stem cell(CFU-GM)으로부터 분화되어 나누어지는데 호중구는 myeloblast로부터 promyeloeyle, myelocyte, metamyelocyte, band neutrophil을 거쳐 완전히성숙된 segmented neutrophil이 된다(그림 참조). 많은 수의 호중구는 골수에 존재하며 말초혈액에는 그중 일부(40%정도) 만이 순환하다가 조직으로 빠져나가 탐식기능을 담당하다가 파괴된다. 단구는 promonocyte를 거쳐 성숙되는데 골수에서는 짧은 기간 존재하고 말초혈액으로 나와 20~40시간 순환하다가 조직으로 가서 대식세포(macrophage)로 변환된다.
- 이들 세포의 생성조절은 colony stimulating factor(CSF)의 feedback 작용으로 이루어진다고 생각되고 있다.
- (2) 림프구(lymphocyte)
- 흉선으로 가서 분화된 림프구를 T림프구라 하고 조류의 "bursa of Fabricius"에 해당되는 기관에서 분화된 세포를 B림프구라고 하는데 인간에서 B림프구는 골수에 남아있는 간세포로부터 분화된다.
- - B림프구 : 간세포에서 항원자극 없이도 분화가 일어나 pre-B 단계를 거쳐 성숙한 B림프구로 분화된다. 항체를 생산하는 형질세포로 분화하려면 항원자극이 필요하다.
- - T림프구 : 흉선에서 T림프구는 early thymocyte, common thymocyte를 거쳐 ma-ture thymocyte가 되고 이 단계에서 helper와 suppressor T림프구로 분화될 세포로 나뉜다. 말초혈액으로 나오면서 성숙한 helper 및 sup-pressor T 림프구가 된다.
-
- 3) 혈소판 생성
- 혈소판은 megakaryoblast 에서 분화된 megakaryocyte의 세포질이 떨어져 나와 생성되는데 각각의 megakayocyte는 약 4000개의 혈소판을 생성하여 간세포(CFU-Meg)로부터 혈소판이 생성되는데 약 10일이 소요된다.
- 말초혈액으로 나온 혈소판은 비장에 1일정도 머물다 순환되는데 골수에서 생성되는 혈소판의 약 1/3까지는 비장에서 정체될 수 있다.
-
- 이와같은 골수를 검사하는 것은 :
- ① 혈액 질환의 진단.
- ② 치료의 효과
- ③ 질병의 경과
- ④ 악성 종양 등의 골수 전이(metastasis) 의 유무 등을 알아보기 위한 목적으로 실시하는 것이다.
- 골수천자 (bone marrow aspiration) 는 보통의사가 행하는 것으로 되어 있으나 골수 도말이나 골수액으로 하는 검사는 임상병리사가 취급하는 것이므로 이에 대한 일반적인 상식 정도는 알고 있어야만 하겠다.
- 골수의 생검 검사 (biopsy) 는 1876년 Mosler 가 regular wood drill을 사용하여 생체 내 골수 생검을 실시한 것을 시초로 하여, 1908 년 Ghedini 가 현재와 비슷한 것을 처음 사용한 이래 20년 후인 1928년 Arinkin 에 의해 골수천자침 (needle aspiration of the marrow)이 사용되었다고 보고되고 있다. 최근에는 더욱 많은 발전을 가져오고 있다.
- 골수는 연령에 따라 변화하는데 유아기에는 대개 뼈 전부가 적골수이었다가 5∼6세가 되면 일부는 지방(fat)으로 대치되고 16∼18세가 되면 완전히 적골수와 황골수로 구분되어진다. 성인의 적골수는 늑골(ribs), 흉골(sternum), 두개골(skull), 견갑골(spacule), 쇄골 (clavicle), 장골 상단(epiphyses of the long bone), 골반(pelvis) 및 척추골(vertebrae)등에 존재한다.
-
- 2. 골수의 구조 및 기능 (Bone Marrow structure and function)
-
- (1) 일반구조 (General structure)
-
- Sponge bone 사이에 존재하며, 혈관, 신경, 망상세포 , 섬유(fibres), 지방세포 및 조혈세포, 림프세포를 포함하고 있다. 혈관의 조성물은 소동맥, 동맥 모세혈관, 정맥동 (sinusoid), 및 정맥으로 구분되는데, 영양동맥이 뼈를 뚫고 들어와 소동맥으로 나뉜다. 림프관은 없다.
-
- (2) 조혈 유도 미세환경 (Hematopoietic inductive microenvironments)
-
- 조혈세포들이 자랄수 있는 장소를 제공하고, 조혈세포가 일정한 방향으로 분화 (differentiation)되어가도록 조정하는 역할을 하는 환경으로 혈관, 골, 지방, 조골세포 , 내피세포, 망상세포, 림프구, 및 섬유 등으로 구성되어 있다.
-
- (3) 골수 구조와 조혈세포와의 관계
-
- ① 뼈 주위에는 과립구의 어린 미성숙한 세포들이 모여있다. (주로 백혈병 초기에 많이 볼수 있다.)
- ② 소동맥 주위에는 과립구가 생성되고 때로는 형질 세포가 모여있다.
- ③ Sinus 주위에는 거핵세포와 적혈구들이 만들어지며, 골수에서 만들어진 모든 혈구들이 말초혈액으로 나가는 곳이다.
-
- (4) 골수의 각 구조물의 정상 분포
-
- 조혈조직 : 40%, 지방조직 : 28%, 뼈 :26%, 골양(osteoid) : 0.3%, 정맥동 : 4,5%
- 형질세포 : 21개/㎣, 비만세포 : 2개/㎣, 거핵세포 : 8개/㎣, 거식세포 : 16개/㎣ 등으로
- 되어 있다.
-
- 3. 골수 검사 (Bone marrow examination)
-


- 1) 골수 검사시 시행 대상
-
- ① 임상적으로 혈액 질환이 의심되는 림프절, 비장, 간의 증대가 있을 때
- ② 말초혈액의 소견이 백혈병을 의심하게 하는 경우
- ③ 원인을 알 수 없는 심한 빈혈, 혈소판 감소, 백혈구 감소가 있을 경우
- ④ 뼈의 방사선 소견에서 혈액 질환이 의심되는 경우
- ⑤ 암의 전이 여부를 확인하고자 할 경우
- ⑥ 육아종의 세균학적 또는 병리조직학적 검사를 목적으로 할 경우
- ⑦ 비장 적출을 위하여 골수의 기능을 평가할 경우
- ⑧ Storage diseases의 진단을 위하여
- ⑨ 빈혈, 백혈병등의 치료효과와 예후의 판정을 위하여
- ⑩ 다발성 골수종의 진단을 할 경우
- ⑪ 면역 globulin의 이상이 있는 경우
- ⑫ 골 질환의 진단을 할 경우 등이 대상이 된다.
-
- 반면에, 골수 검사를 시행해서는 안되는 경우는, 혈우병환자, 혈소판 수 감소에 의한 출 혈성 소인이 있는 경우, 유혈우병군, 중증 호흡기질환, 순환기질환이 있는 경우이다.
-
- 2) 골수천자부위 (sites)
-
- 골수는 연령이 많아질수록 지방화되기 때문에 지방화가 빠른 장관골의 천자는 피하고 cellular marrows 로 되어 있는 부위를 선정하여야만 한다. 천자하기 쉬운 부위는 뼈가 피부에 가깝고, 골 피질이 얇고 골 수질은 두꺼운 부분이 좋으며, 천자부위 바로 아래에 중요한 장기가 있는 곳은 적당치 않다. 성인은 흉골(sternem), 후장골능(posterior iliac crest), 척추극돌기(spinous process of vertebra), 늑골(rib)들이 선택된다. 유아, 소아는 경골(tibia),
- 전장골능 (anterior iliac crest)이 선택된다.
- 후장골능은 특히 모든 연령층에서 생검이나 천자를 할 수 있는 부위이며 흉골은 15세 이상의 어른에게만 천자를 할 수 있는 부위이다. 그러나 성인에게서 번번히 이용되고 있는 곳은 흉골이며 그 해부도는 다음과 같고 제2내지 제3늑간이나 흉골병 부분이 주로 이용된다.
-
- 3) 골수 천자시 필요한 기구 및 시약
-
- ① Illinoss aspiration needle (천자용)과 Jamshidi bidpsy needle (생검, 천자용) 두가지가 있다. 천자침은 내침(stylus), 외투침(puncture needle), 보호판(guard)의 3부분으로 되어 있는데 각 침의 끝 부분은 예리하게 되어 있어 천자하기에 편리하도록 되어 있다. 그리 고 보호판으로 일정한 거리에서 멈추게 하여 뼈의 관통을 막도록 되어 있다. 2조 준비한 다.
- ② 건조한 주사기 20㎖ 용으로 2조 준비한다.
- ③ 마취용 주사기
- 마취제로는 1% procaine 이나 1% lidocaine 액.
- ④ WBC 피펫과 Turk 용액.
- ⑤ Slide glass 8장 , cover glass 4장 및 watch glass.
- ⑥ Wintrobe or heparinized capillary tube 및 sealer.
- ⑦ 고정액 10% formalin 및 각 세포화학용 고정액을 준비.
- ⑧ 소독에 필요한 기구
- 요-드액, 알코올, 소독솜, 꺼-즈 등
-
- 4) 후장골능에서의 천자 및 생검 방법
-
- 환자에게 사전에 지식을 주어 협조를 요청한다. 옆으로 눕혀 등을 구부리고 무릎도 약간 구부리게 한다. 천자부위를 요-드와 알코올로 넓게 소독하고 천자부위만 노출되도록 구멍 방포를 덮는다. 24G로 1% procaine으로 피부와 피하조직을 마취하고 천자와 생검에 필요한 면적(직경이 약 2㎝ 정도)의 골막을 마취시킨다. 이 때 혈관 내 직접 주입은 불가하다. 내침이 잠겨진 상태에서 피부에 수직으로 세우고 바늘을 돌려 피부 속으로 넣는다. 바늘이 뼈에 닿았을 때 바늘 전체를 좌우로 3번 돌리며 (약 3㎜ 정도)힘을 가하면 바늘이 골수에 들어갈 때에 갑자기 저항이 감소됨을 느끼게 될 것이다. 바늘이 골수로 들어가면 내침을 빼고 주사기를 연결하여 빠르고 강하게 흡인하여 0.2∼0.5㎖ 골수가 나오도록 한다. 이때 너무 많은 양이 흡인되어 나오면 sinusoidal 혈액으로 희석된 것이라고 볼 수 있다.
- 한편, 골수 천자액을 흡인할수 없는 경우 (dry tap)도 있을 수 있다. 이 경우는 세포 증식이 대단히 많아서 골수혈이 비유동적일 때이거나, 골수가 저형성이거나 섬유조직의 증식이 심할 때 즉, 골수 섬유종, 무형성 빈혈, hemochromatosis, 림프육종, 대리석병일때이므로 이때는 생검(biopsy)을 해야 한다.
- 생검시에는 천자부위 골막에서 1㎝상방으로 떨어진 곳에서 내침을 낀 Jamshidi 바늘을 넣고 전방 쪽으로 바늘을 향하여 돌려 넣는다. 저항이 줄면 골수에 들어간 것이므로 내침을 빼고 생검침을 천천히 돌려 가면 2㎝정도 넣은 후 생검 침을 여러번 완전히 회전시킨다음 천천히 좌우로 돌려가며 바늘을 빼고 탐침(probe)을 바늘의 하단부부터 집어 넣어 조직을 꺼내 조심스럽게 slide 위에 touch print 하여 고정액에 넣는다.
- 천자또는 생검이 끝나면 소독된 꺼-즈로 덮고 모래주머니로 압박시켜 지혈되도록 하며
- 1시간 정도 침상에서 안정을 취하도록 한다.
-
- 5) 골수 검사 종목
-
- 채혈된 골수혈은 말초혈보다 점조성이 강하여 곧바로 응고되기 쉬우므로 채혈즉시 각 검사 종목을 위한 조치를 위하여야 한다. 이 작업이 정확하게 되어야 골수 검사의 목적이 달성될 수 있다.
-
- (1) 유핵세포 수 산정
-
- 말초 혈액이 섞이지 않도록 주의하여야 하고 골수혈의 일부라도 응혈되면 안되므로 채혈 즉시 watch glass 에 받아 놓은 것을 가지고 즉시 WBC 피펫을 사용하여 채취한 후 바로 Turk 액으로 희석하여 산정한다. 정상치는 5∼20만/㎣ 이다.
-
- (2) 거핵구 수 산정
-
- 유핵세포 수 산정과 같은 방법으로 채혈 즉시 산정 한다. 정상치는 40∼150개/㎣이다.
-
- (3) 골수 용적 측정(Myelocrit)
-
- 채혈 즉시 골수혈을 항응고제로 처리하여 Wintrobe tube 에 넣고 30분간 3,000 RPM 으로 원침(macro method)하든지 또는 heparin 처리한 모세관에 넣어 한 쪽을 봉하고 12,000RPM으로 5분간 원침(micro method) 하여 보면, 위로부터 지방, 혈장, 유핵세포, 적혈구층으로 구분되어 침전되는 것을 볼 수 있다. 이는 질병이나 연령에 따라 차이가 있다. 정상 성인의 경우 지방층 1.7%, 혈장층 52.5%, 유핵세포증 6.4%, 적혈구층 39.4% 정도 된다. 재생불량성 빈혈 (aplastic anemia)에서는 지방층이 증가하고 유핵세포층과 적혈구층은 감소하는데 ,백혈병에서는 유핵세포등이 증가한다. 또 polycythemia vera 에서는 재생 불량성 빈혈에서는 반대 현상이 나타낸다.
-
- (4) 도말표본 작성 및 검경
-
- 골수혈은 응고되기 쉬우므로 신속하게 도말을 해야만 한다. 혈액 도말과 같은 방법으로 박층 직접 도말 4장 이상, 농축도말 2장 이상, 그리고 입자 도말 2장 이상을 만든다. 염색은 일반적으로는 Wright stain 이나 Giemsa stain, Sudan black B stain, PAS stain, alkaline phosphatase stain. prussian blue stain 및 esterase stain 등을 실시한다.
- 골수의 도말표본이 얻어지면 광학현미경을 사용하여 약 확대로 전체적인 세포의 분포상태를 관찰한 후 균등한 분포가 되어있는 곳에서 유침렌즈로 이상세포의 유무와 500∼1,000개의 유핵세포를 세어 골수 백분율 (골수상, myelogram)을 산출한다. 이때에 혈액내 기생충의 관찰도 하면 좋다. 검경할 때 다음의 사항을 유의하면 참고가 될 것이다.
- ① M-E ratio (골수계- 적혈구계 비 : Myeloid-Erythroid ratio) ; 정상범위는 2:1∼5:1
- Erythoid hyperplasis : 용혈성 빈혈, 진성 적혈구 증다증, 철 결핍성 빈혈, 악성 빈혈 등
- Erythoid hypoplasis : 림프육종, 다발성 골수종, 재생 불량성 빈혈, 백혈병
- Mydloid hyperplasis : 백혈구 증다증, 재생 불량성 빈혈, 다발성 골수종
- Myeloid hypolplasis : 백혈병
- ② 이상세포 관찰
- 종양세포, 조직세포 등
- ③ 말라리아, histoplasmosis, leishmaniasis 등의 혈액 기생충 관찰
-



- ④ Fe 반점 관찰
- 감소하면 IDA(철결핍성 빈혈), 증가하면 용혈성 빈혈, sideroblastic 성 빈혈 간경변증
-
-
- 골수 표본의 관찰은 세포의 백분율보다 세포의 경향을 관찰하는 것이 더 중요하다. 특수 염색은 백혈병이나 그 외의 이상 백혈구가 보일 때, 그 세포가 어느 계통의 백혈구 인지를 분명하게 알고자 할 때 시행한다.
-
- Special stains of B.M
-
- PAS(Periodic Acid Stain)
- 1. 검사명 : PAS(Periodic Acid Stain)

- 2. 검사원리 : 백혈구 및 적아구에는 polysaccharide, mucopolysaccharides, mucoprotein, glycoprotein 등이 존재한다. 이들 protein과 결합된 carbohydrate기가 periodic acid에 의해 산화되어 aldehyde 기를 생성하고 이것이 Schiff's reagent와 작용하여 붉은 자주색을 띈다.
-
- 3. 검체 채취 용기 및 검체 적합성 판단기준
- 1) Formalin에 오염되지 않은 slide
- 2) 항 응고제(EDTA)가 들어있는 혈액이나 골수 도말한 slide
- 3) 너무 희석되지 않은 검체로 만든 slide
-
- 4. 시약
- 1) Periodic acid sol.(periodic crystal 5g을 100ml DW에 녹여서 사용)
- : 냉장고에 보관하고 사용전에 실온으로 되게하여 사용하며 유효기간을 적어놓는다.
- 2) Schiff's reagent
- : 냉장고에 보관하고 사용전에 실온이 되게한다.
- 3) Mayer hematoxylin solution
- 4) 고정액(Alcoholic formalin)
- : 37% formalin 10ml + ethanol 90ml
-
- 5. 정도관리 물질 : neutrophil이 많은 slide
-
- 6. 장비 : microscope
-
- 7. 검사방법
- 1) 말초혈액이나 골수도말표본을 공기중에 말리고 고정액에 10-15 분 고정한 후 흐르는 물로 15분간
- 수세 한다.
- 2) Periodic acid에 10 분간 놓아둔다.
- 3) 흐르는 물에 10분간 세척한다.
- 4) Schiff reagent로 37에 30분간 염색한다.
- 5) sulphurous acid 에 10분간 놓아둔다.
- 6) 흐르는 물에 충분히 5 분정도 세척한다(pink color).
- 7) Mayer hematoxylin에 30 분간 대조 염색한다.
- 8) 흐르는 물에 10분동안 세척한다.
- 9) 공기중에 말린 후 봉입하여 현미경으로 관찰한다.
-
- 9. 결과 및 보고방법
- 1) Neutrophil과 megakaryocyte는 양성을 보이며 분홍색이나 적색으로 보인다.
- 2) Monocyte는 fainty pink색의 fine or coarse granules를 가진 것으로 보인다.
- 3) Erythrocyte는 염색되지 않는다.
- 4) Lymphocyte나 lymphoblast는 양성으로 보일 수도 있다.
-
- 10. 검사 결과의 임상적 의의
-
|
cell type |
PAS Reaction |
|
Myeloblast
Promyelocyte, myelocyte and metamyelocyte
Band and neutrophil
Lymphoid cell
Monocyte
Platelet and megakaryocyte
Normoblast
Reed-Sternberg cell
Sezary cell, Gaucher cell myeloma cell and histiocyte
Amyloid, reticulin and fibrin |
negative or rarely weakly positive
diffusely mildly positive
diffusely strongly positive
negative or a few small PAS positive granules
fine pink granules or a few small PASpositivegranules
diffuse red staining andscattered redgranulation,rarely a few fine pink granules
rarely a few fine pink granules negative
may be positive
may be positive
|
11. 참고문헌
- 1) Hyun BH, Gulati GL, Ashton JK : Color Atlas of Clinical Hematology, Igaku-shoin, New York, Tokyo, 1986, pp. 58-60
- 2) Li CY, Yam LT, Sun T : Cytochemistry(pp. 7-19), Cytology and Cytochemistry(pp. 112-127) in Modern Modalities for the Diagnosis of Hematologic Neoplasms, Igaku-shoin, New York and Tokyo, 1996
-
- Non-specific Esterase Stain

-
- 1. 검사명 : Non-specific Esterase Stain
-
- 2. 검사원리 : 백혈구의 esterase는 naphthalene derivative를 가수분해하여 naphthol compound를 내는데 이것이 diazonium salt와 결합하여 enzyme activity가 있는 부위나 혹은 그 주위에 colored precipitate를 만든다.
-
- 3. 검체 채취 용기
- 1) Formalin에 오염되지 않은 slides
- 2) EDTA 항응고제가 섞인 혈액이나 골수로 도말한 표본
-
- 4. 검체 적합성 판정 기준
- 1) 너무 희석된 검체로 만든 slide는 부적당하다.
- 2) 당일검체를 사용하며 가능하면 빛의 노출을 차단한다.
-
- 5. 시 약
- i. None specific esterase stain( Sigma, USA )
- 1) 고정액 : Citrate solution-------------------------------------- 50ml
- (citrate Sol. 25ml + acetone 65ml + 37% formaldehyde 8ml)
- 2) 반응액
- - α-naphythyl butyrate solution, (냉동보관)
- - pararosaniline solution (냉장보관)
- - sodium nitrite tablets (냉장보관) : DW 62.5ml + 10 tablets
- - phosphate buffer (냉장보관) : DW 500ml 혼합 pH 7.7
- - citrate solution (냉장보관)
- 3) 대조 염색액
- - methylene blue solution (냉장보관)
-
- 6. 장비 : Microscope
-
- 7. 검사방법
-
- ① Phosphate buffer 40ml을 coplin jar에 넣고 37에 5분간 넣어둔다.
- ② 1.5ml sodium nitrite solution 1.5ml 에 pararosaniline solution 1.5ml을 ①에 첨가한다.
- ③ α-Naphthyl butyrate solution 5ml을 에 첨가한다.( 냉동실에서 거내 37℃ 에 prewarm 한다.)
- ④ 10 초간 고정액 (citrate-acetone-formaldehyde)에 고정한 후 반드시 증류수로 세척한다.
- (* slide를 건조시키면 안된다.)
- ⑤ 37℃ 에 1시간 incubation 한다.
- ⑥ tap water로 2-3분간 세척한다.
- ⑦ 5분간 methylene blue counter stain 한다.
- ⑧ D.W.로 세척한다.
- ⑨ 봉입하여 검경한다.
-
- 8. 결과 및 보고방법
|
Cell Types |
Nonspecific Esterase Reaction |
|
monocytes and precursors
histiocytes
megakaryocytes and platelets
lymphocytes and precursors
neutrophils, eosinophils and their precursors
basophils and precursors
plasma cells
normoblasts
hairy cells
megaloblasts |
strongly positive
strongly positive
strongly positive
negative or localized weak positivity
negative or weakly positivity
negative
negative to moderately positive
negative or weakly positivity
moderately or strongly positive
moderately or strongly positive |
- 1) 양성 : 단구에는 α-naphthyl acetate activity가 있으므로 양성이다.
- megakaryocytes, histiocytes
- 2) 약양성 : 비정형 림프구, 림프종의 분화가 안된 림프구
- 3) 음성 : 호중구 과립구의 전구 세포
-
- 9. 참고문헌
- 1) Hyun BH, Gulati GL, Ashiton JK : Atlas of Clinical Hematology, Igaku-shoin, New York and Tokyo, 1986, pp. 58-60
- 2) Li CY, Yam LT, Sun T : Cytochemistry(pp. 7-19), Cytology and Cytochemistry(pp. 112-127) in Modern Modalities for the Diagnosis of Hematologic Neoplasms, Igaku-shoin, New York and Tokyo, 1996
- 3) Sigma Diagnostics Insert, Naphthol AS-D Chloroacetate esterase and α-Naphthyl Acetate Esterase(Procedure No. 91), 1995
- 4) (주)시약화학약품(Budoh Chemical) Insert, NSE with NaF Inhibition Test, 동경
-
- Iron Stain
- 1. 검사명 : Iron Stain
-
- 2. 검사원리 : 이온화 철이 acid ferrocyanide와 반응하여 ferric ferrocyanide를 형성하여 파랗게 염색 됨으로 세포나 골수내에 저장 철의 정도를 관찰한다.
-
- 3. 환자준비 : 없음
-
- 4. 검체 채취용기 : 철이 오염되지 않은 slide에 도말한다.
-
- 5. 검체 적합성 판정기준
- 1) 적어도 30 분 이상 공기중에 건조된 도말이어야 한다.
- 2) Absolute methanol에 10 분정도 고정이 끝난 도말이어야 한다.
-
- 6. 정도관리 : 매 염색시 철 결핍환자가 아닌 사람의 골수 도말표본과 함께 실시하여 양성 control로 삼는다.
-
- 7. 시약
- 1) 고정액 : methylalcohol
- 2) 염색액
- (1) 4% potassium ferrocyanide ----------------------- 50ml
- (pot. ferrocyanide + DW 50ml)
- (2) 4% Hcl --------------------------------------- 50ml
- (conc. HCl 40ml + DW 340ml)
- 3) 대조염색 :
- 0.1% neuclear fast red
-
- 8. 장비 : Microwave oven, plastic cup
-
- 9. 검사방법
- 1) methylalcohol에 30분 이상 고정한다.
- 2) 동량의 4% pot. ferrocyanide와 4% HCl sol. mixture에 담근다.
- 3) 염색액에 slide를 담근 후 micro oven에 놓고 가열한다.
- (1) 조리 약(200W) : 50sec ------------ 현재 사용법
- (2) 해동 약(500W) : 2 분 10 초
- 4) 증류수로 충분히 세척한다.
- 5) fast red로 5 분간 염색한다.
- 6) 증류수로 세척한 후 봉입한다.
-
- 10. 결과 및 보고방법
- 1) 골수에서는 iron particle이 histiocyte 안에서 푸른색으로 보이므로 저장 철 정도를 판정하고 핵이 있는 적혈구에서 세포질 내 작은 particle이 보일 경우 이것을 sideroblast라고 하며 만일 이것이 핵 주의에 granule로 둘러쌓여 있으면 ringed sideroblast라 부른다.
- Hemosiderin :Blue
- Nuclei :Red
- Red cell cytoplasm : Pink-rose
-
- 2) RBC내의 Pappenheimer bodies도 양성으로 보인다.
-
-
- 11. 참고치
- 1) stainable iron(저장철)
- - : absent
- ± : decreased
- 1+ : normal
- 2+ : midly increased
- 3+ : moderately decreased
- 4+ : markedly decreased
- 2) Sideroblast & ringed sideroblast
- : 100개의 erythroblast중 sideroblast와 ringed sideroblast 수를 count한다.
-
- 12. 검사 결과에 영향을 미칠수 있는 사항
- 1) 모든 기구는 철이 오염되지 않은 증류수로 처리한다.
- 2) 철의 오염을 주의하면서 세척은 반드시 증류수로 한다.
-
- 13. 참고문헌
- 1) Li CY, Yam LT, Sun T : Cytochemistry(pp. 7-19), Cytology and Cytochemistry(pp. 112-127) in Modern Modalities for the Diagnosis of Hematologic Neoplasms, Igaku-shoin, New York and Tokyo, 1996
- 2) Hyun BH, Gulati GL, Ashiton JK : Special Stains in Hematology in Color Atlas of Clinical Hematology, Igaku-shoin, New York and Tokyo, 1986, pp. 45-66
-
- Myeloperoxidase stain
-
- 1. 검사명 : Myeloperoxidase Stain
-
- 2. 검사원리 : 백혈구의 peroxidase는 hydrogen peroxide에 대해 여러가지 기질들의 산화반응에 촉매 역할을 하는 효소로 효소활성도에 따라 deep brown color의 염색물질을 형성하며 다음과 같은 원리에 의해 염색된다.
-
-
- 3. 시 약(sigma)
- 1) Fixative solution(fresh, made daily)
- 37% formaldehyde ----------------------------- 5ml
- 95% ethanol ------------------------------------- 45ml
- 2) 염색액
- O- toluidine 250mg in ethanol : 6ml
- sigma T 8533 25g (minimum 97%)
- 증류수 : 4ml
- 신선한 3% 과산화수소 : 1-2 방울 -- 침전이 많을 경우 여과한다.
-
- 4. 검사방법
- 1) 고정액으로 30초간 고정시킨다.
- 2) 흐르는 물로 씻은후 공기중에서 말린다.
- 3) 사용전에 바로 만든 염색액을 slide위에 얹고 15분간 실온에서 반응시킨다.
- 4) 흐르는 물로 2분간 씻은 후 공기중에서 말린다.
- 5) wright stain후 mounting 하여 관찰한다.
-
- 5. 결과 및 보고방법
- 1) 양성 : 과립구계(primary granules of neutrophils and granules of eosinophils) 및 그 구체들(brown intracellular granulation)
- 2) 약양성 : 단구계
- 3) 음성 : 기타 혈구
-
- 6. 검사결과의 임상적 의의 : 급성 백혈병의 blast가 myeloid(양성)인지 lymphoid(음성)인지를 구분 할 수 있으므로 ALL과 AML을 감별하는데 사용된다.
|